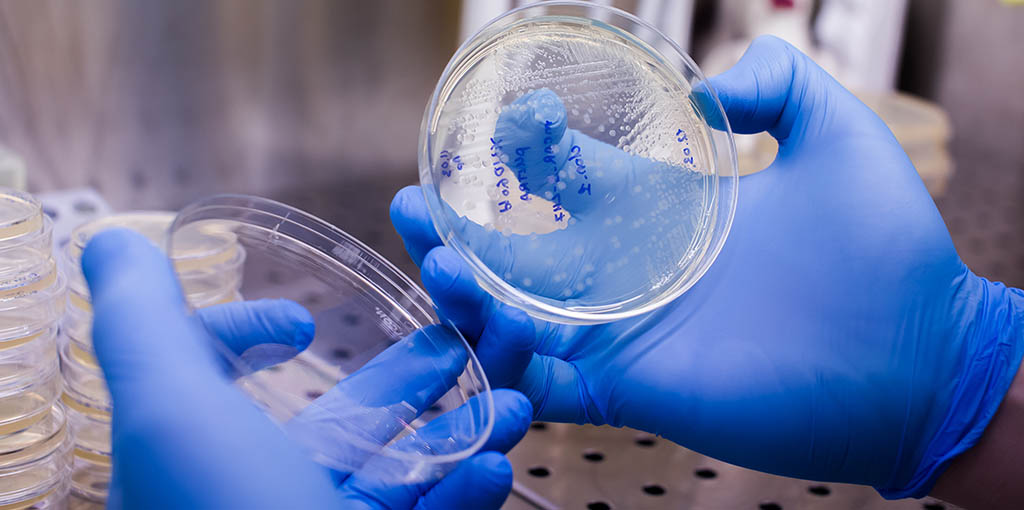
Evading exhaustion to improve CAR-T cell therapy - Scope

Treatment and Outcome Analysis of 639 Relapsed Non-Hodgkin Lymphomas in Children and Adolescents and Resulting Treatment Recommendations - PubMed
Source : https://pubmed.ncbi.nlm.nih.gov/33923026/
Despite poor survival, controversies remain in the treatment for refractory or relapsed pediatric non-Hodgkin lymphoma (r/r NHL). The current project aimed to collect international experience on the re-induction treatment of...
-
 Naveed Saleh, MD, MS – Skipta Team4yrKey Points • The treatment for refractory or relapsed non-Hodgkin lymphoma (r/r NHL) in children and adolescents is controversial. In order to make treatment recommendations, researchers pooled international experiences on re-induction Show More
Naveed Saleh, MD, MS – Skipta Team4yrKey Points • The treatment for refractory or relapsed non-Hodgkin lymphoma (r/r NHL) in children and adolescents is controversial. In order to make treatment recommendations, researchers pooled international experiences on re-induction Show More

Detection of CAR-T19 cells in peripheral blood and cerebrospinal fluid: An assay applicable to routine diagnostic laboratories - PubMed
Source : https://pubmed.ncbi.nlm.nih.gov/33915021/
The assay enabled routine monitoring of CAR-T19 in blood and CSF samples. Despite profound cytopenia in many lymphoma patients, results were obtained regularly from only 4 ml of blood. The...
Evading exhaustion to improve CAR-T cell therapy - Scope
Source : https://scopeblog.stanford.edu/2021/05/05/evading-exhaustion-to-improve-car-t-cell-therapy/
'Resting' exhausted cancer-fighting immune cells enhances their tumor-killing activity, which may help people with blood and solid cancers. Even cells need a rest sometimes. In 2017, I had the privilege...

A prognostic immune risk score for diffuse large B-cell lymphoma - PubMed
Source : https://pubmed.ncbi.nlm.nih.gov/33942291/
We constructed a prognostic score for persons with diffuse large B-cell lymphoma (DLBCL) based on infiltrating immune cells. Data of 956 consecutive subjects were retrieved from the Gene Expression Omnibus...

Reduced radiotherapy clinical benefit for primary Waldeyer's ring diffuse large B‐cell lymphoma in the rituximab era
Source : https://onlinelibrary.wiley.com/doi/epdf/10.1002/hon.2869
ORIGINAL RESEARCH ARTICLE Corresponding Author Departments of Lymphoma, Tianjin Medical University Cancer Institute and Hospital, National Clinical Research Center of Cancer, Key Laboratory of Cancer Prevention and Therapy, Tianjin's Clinical...
-
 Mark Fesler4yrThis data is consistent with most reports in the rituxan era of the limited value of xrt for most cases of limited stage dlbcl treated with immunochemotherapy
Mark Fesler4yrThis data is consistent with most reports in the rituxan era of the limited value of xrt for most cases of limited stage dlbcl treated with immunochemotherapy
